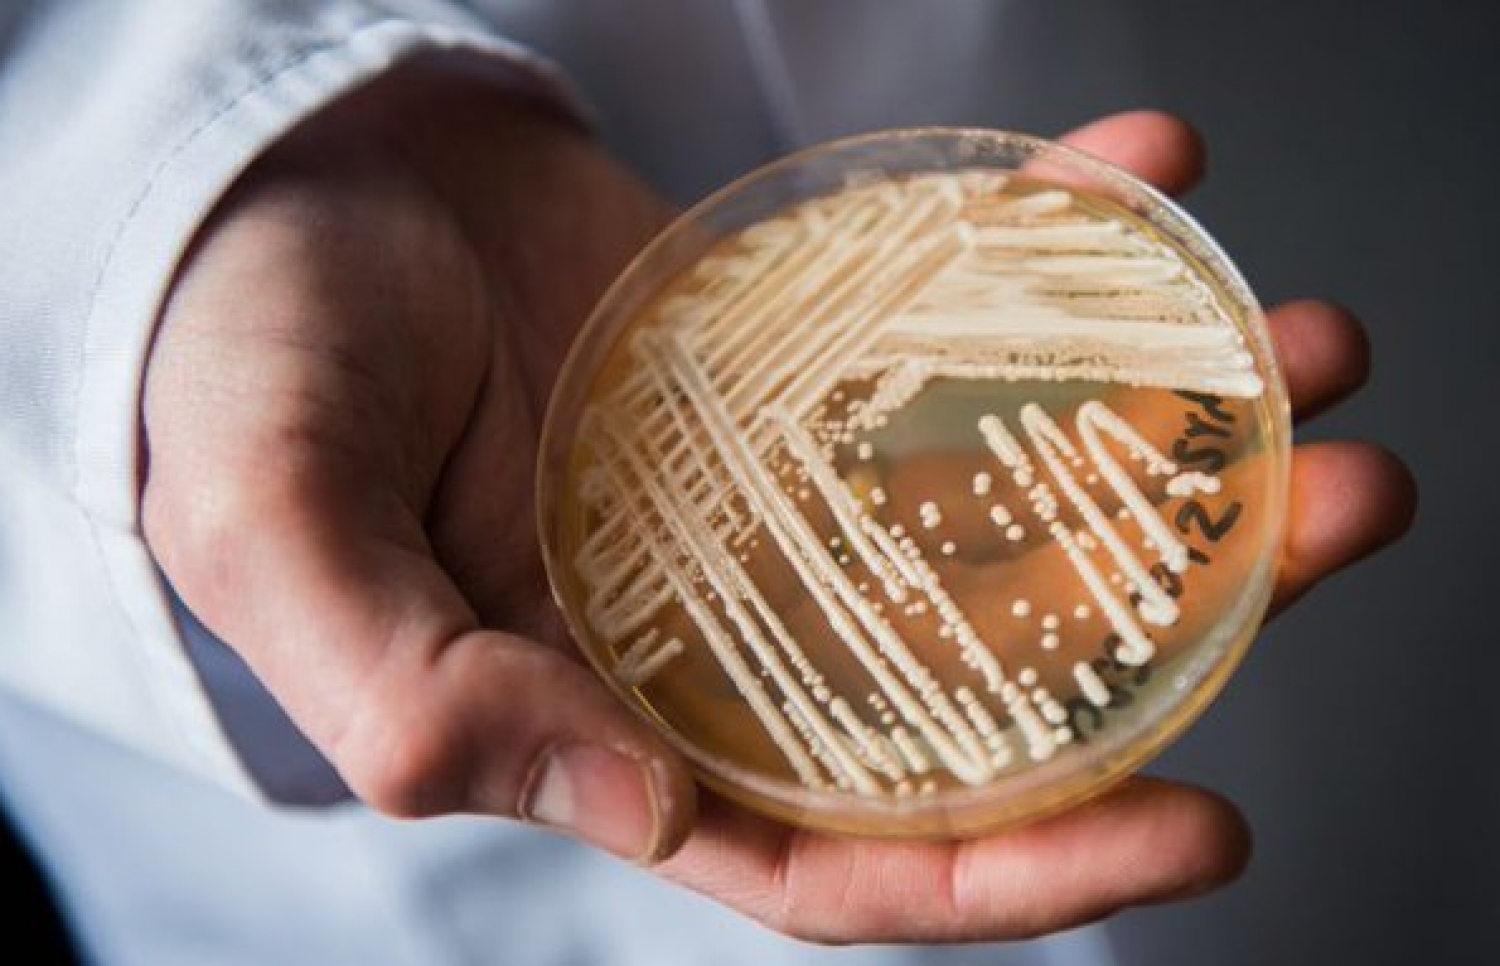
ކެންޑިޑޭ އޯރިސް ނުވަތަ ސީ އޯރިސ ފަންގަސް

ވަރަށް ނުރައްކާތެރި ފަންގަސްއެއް އެމެރިކާގައި އާދަޔާ ޚިލާފަށް ހަލުވިކަމާއެކު ފެތުރެމުން ދާތީ، އެކަމާ ބެހޭ ގޮތުން އަޅަންޖެހޭ ރައްކާތެރިކަމުގެ ފިޔަވަޅުތައް އެޅުމަށް، އެ ގައުމުގެ ސެންޓާސް ފޯ ޑިސީސް ކޮންޓްރޯލް އެންޑް ޕްރިވެންޝަން އިން އާންމުކޮށް އަންގައިފި އެވެ.
އެ މަރުކަޒުން ބުނި ގޮތުގައި "ކެންޑިޑޭ އޯރިސް" ނުވަތަ ސީ އޯރިސް ކިޔާ މި ނުރައްކާތެރި ކަޅު ފަންގަސް، އެ ގައުމުގެ ސިއްހީ ހިދުމަތް ދޭ މަރުކަޒުތަކާއި ހޮސްޕިޓަލުތަކުގައި 2020 ވަނަ އަހަރާއި 2021 ވަނަ އަހަރު ވެސް ވަރަށް ބޮޑަށް އާލާވެ ފެތުރުނެވެ. އަދި 2022 ވަނަ އަހަރުވެސް، ކަންބޮޑުވާންޖެހޭ މިންވަރަކަށް ސީ އޯރިސް ފެތުރިފައިވާ ކަމަށް އެ އިދާރާ އިން ބުންޏެވެ.
އިންސާނާގެ ހަށިގަނޑުގައި މި ވައިރަސް އާލާވާން ފެށުމުން، ކަންފަތުގެ އެތެރޭގައި ފާރު އުފެދި ލޭގެ ނިޒާމުގެ ތެރޭގައި ޖަރާސީމު އަށަގަނެ އެވެ. އަދި ހަށިގަނޑުގެ އެކި ތަންތަން ފާރުވެ އެވެ. މި ފަންގަސް އާންމު ގޮތެއްގައި އިންސާނުންގެ ތެރެއިން އާލާވަނީ ހަށިގަނޑުގެ ދިފާއީ ނިޒާމު ބަލިކަށި މީހުންގެ ގައިގަ އެވެ.
އެހެންކަމުން މި ފަންގަސްއަކީ ސިއްހަތު ރަނގަޅު މީހުންނަށް މާ ބޮޑު ނުރައްކަލެއް ނޫން ކަމަށް، އެމެރިކާގެ ސެންޓާސް ފޯ ޑިސީސް ކޮންޓްރޯލް އެންޑް ޕްރިވެންޝަން އިން ބުނެ އެވެ. ނަމަވެސް ހަށިގަނޑުގެ ދިފާއީ ނިޒާމު ބަލި މީހުންނާއި ބޮޑެތި ބަލިތަކަށް ބޭސްކުރާ މީހުންނާއި މުސްކުޅިން ބަލަހައްޓާ ގެތަކުގައި އުޅޭ މީހުންނާއި ހޮސްޕިޓަލުތަކުގައި ދިގު މުއްދަތަކަށް އެޑްމިޓްކޮށްފައި ތިބޭ މީހުންނަށް، މި ފަންގަސްގެ ނުރައްކާ ބޮޑެވެ.
އެމެރިކާގައި ޖުމްލަ 50 ސްޓޭޓް އޮންނަ އިރު އޭގެ ތެރެއިން ދެ ބައިކުޅ އެއްބައި ސްޓޭޓްގައި ކެންޑިޑޭ އޯރިސް ފަންގަސް ފެތުރެމުން ދާ ކަމަށް އެ މަރުކަޒުން ބުނެ އެވެ. އޭގެ ތެރެއިން ވެސް އެންމެ ގިނަ މީހުންނަށް މި ފަންގަސްގެ އަސަރު ކޮށްފައިވަނީ ކެލިފޯނިއާ، ފްލޮރިޑާ އަދި ނިއު ޔޯކުންނެވެ.
މިހާތަނަށް އެމެރިކާ ގައި އެ ފަންގަސްގެ އަސަރުކޮށްގެން ފަރުވާ ދޭން ޖެހުނު މީހުންގެ ތެރެއިން ތިން ބައިކުޅަ އެއްބައި މީހުން މިހާރު މަރުވެފައިވާ ކަމަށް ވެސް އެ މަރުކަޒުން ބުނެ އެވެ.
އެމެރިކާ އިން އެންމެ ފުރަތަމަ މި ބާވަތުގެ ވައިރަސް ފެނިފައިވަނީ 2016 ވަނަ އަހަރުގެ ތެރޭގަ އެވެ. އިންސާނުންގެ ހަށިގަނޑަށް މި ފަންގަސް އެރުމުން ވެސް، ލެބީޓެރީ ޓެސްޓުތަކުން މި ފަންގަސް ދެނެގަތުން އުނދަގޫ ވުމުންނާއި، މިއީ ގިނަ ބާވަތްތަކުގެ ބޭސްތަކަށް ވެސް ނުގުޑާ ފަންގަސްއަކަށް ވާތީ، އެމެރިކާ ސަރުކާރުން ދެކޭ ގޮތުގައި، މި ފަންގަހަކީ ދުނިޔޭގެ އާންމު ސިއްހަތަށް ހުރި ނުރައްކަލެއް ކަމުގައި ބަލަންޖެހެ އެވެ.
އެމެރިކާގެ ސެންޓާސް ފޯ ޑިސީސް ކޮންޓްރޯލް އެންޑް ޕްރިވެންޝަން އިން ބުނާ ގޮތުގައި މި ފަންގަސް އެންމެ ބޮޑަށް ފެތުރިގެން ދިޔަ ކަމަށް ބެލެވެނީ، ކޮވިޑް-19ގެ ބަލިމަޑުކަން އެންމެ ބޮޑަށް ފެތުރެމުން ދިޔަ ދުވަސްވަރު ސިއްހީ ޚިދުމަތްދޭ ތަންތަން ތޮއްޖެހުމުގެ ސަބަބުންނެވެ.

